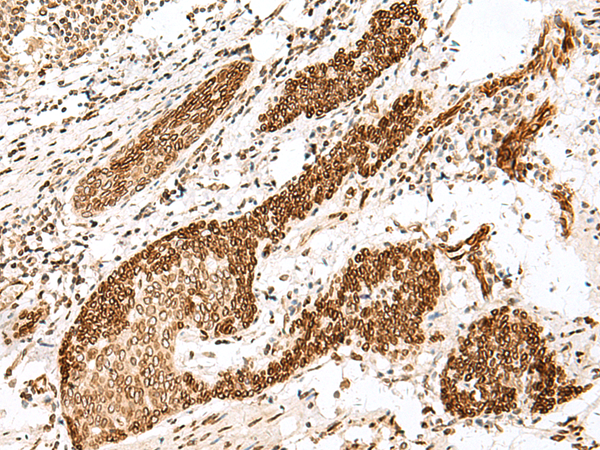

技術規(guī)格
Background:
This gene encodes a member of the Fanconi anemia complementation group B. This protein is assembled into a nucleoprotein complex that is involved in the repair of DNA lesions. Mutations in this gene can cause chromosome instability and VACTERL syndrome with hydrocephalus.
Applications:
ELISA, IHC
Name of antibody:
FANCB
Immunogen:
Synthetic peptide of human FANCB
Full name:
Fanconi anemia complementation group B
Synonyms:
FA2; FAB; FACB; FAAP90; FAAP95
SwissProt:
Q8NB91
ELISA Recommended dilution:
5000-10000
IHC positive control:
Human esophagus cancer and Human thyroid cancer
IHC Recommend dilution:
30-150

購物車
幫助
021-54845833/15800441009
